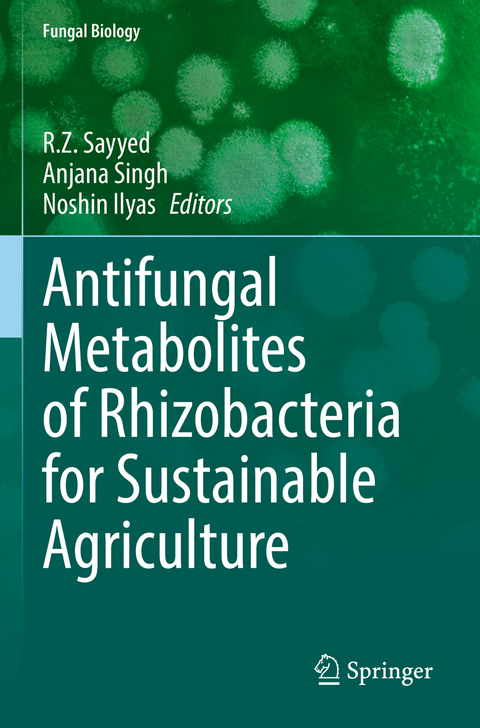
Antifungal Metabolites of Rhizobacteria for Sustainable Agriculture -

Antifungal Metabolites of Rhizobacteria for Sustainable Agriculture
Springer International Publishing (Verlag)
978-3-031-04807-4 (ISBN)
Antifungal Metabolites of Rhizobacteria for Sustainable Agriculture focuses on plant health in agro-ecosystems of various economically important cash and food crops with a concern to promote sustainable agriculture. They have emerged as a key organic tool for enhancing yields. In a natural environment the interactions between plants and phytopathogenic fungi are complex and survival requires a development of resistance to plant diseases. Diversity of Plant Growth Promoting Rhizobacteria (PGPR) diversity depends on the nature of root exudates and soil conditions that affect their interaction with host plants. Novel strategies, such as, applying bioactive natural products against the pathogenic fungus are required to control disease sustainably. Various classes of secondary metabolites including lipopeptides, macrolides, alkaloids, terpenoids and phenolics from microorganisms and plants strongly suppress fungal growth and can also be effective in controlling plant diseases both in vitro and in vivo. The modes of actions of some potential antifungal secondary metabolites against pathogenic fungus are also discussed.
Eco-friendly fungal species and their metabolites are excellent agents used for regulating various fungal and bacterial phytopathogens and may have tremendous potential for other applications, and play a key role in enhancing plant tolerance to stress.
Antifungal Metabolites of Rhizobacteria for Sustainable Agriculture also covers bovine-based formulations used for sustainable production and nutritional security through horticultural crops, thereby addressing the problems associated with malnutrition and under-nutrition encountered by small and marginal farmers, as well as by families facing resource constraints. These techniques can also improve breathable air, drinkable water, and consumable foods. This book addresses the need to mitigate the health problems of peoplevia organic crop production and to improve the socio-economic status of farmers (especially in developing countries), and to revitalize agricultural sustainability.
lt;p>Prof. R.Z .Sayyed is a Professor and Head in Department of Microbiology, PSGVP Mandal's Arts, Science College, Shahada, India. He has over 25 years of teaching and 20 years of research experience in Microbiology and Biotechnology Currently, he serves as the President of the India Chapter of the Asian PGPR Society for Sustainable Agriculture. To his credit, he has received the Best Teachers Award, Young Scientist Award (2005, 2008, and 2012), Prof M M Sharma Award, Springer-Society Award (2020), Award for Excellence in PGPR Research (2017, 2018, 2019). He is Associate Editor of Environmental Sustainability (Springer) and Guest editor of two special issues of Sustainability (MDPI, IF 3.251). He has authored and co-authored over 225 research papers in high IF international journal, 24 books with Springer, Wiley, CRC and Cambridge press and 43 book chapters in reputed edited books. He has Trained several graduates, post-graduate, and research students and produced seven Ph.D.'s under his guidance. He has delivered many invited talks at several Southeast Asian and European Countries.
Prof. Dr. Anjana Singh is a Professor in Central Department of Microbiology (CDM), Tribhuvan University (TU), Nepal. She has been Fulbright post-doctoral fellow at University of Virginia in 2008-09; and recipient of 12 national/international awards. She is an academician of Nepal Academy of Science & Technology (NAST) and in editorial board of Nepal Science and Technology Journal, reviewer of many reputed journals and is coordinator of Women Scientists Forum, Nepal, NAST. She has over 125 national/international publications; has supervised-105 Masters' thesis; 5 PhDs supervised and co. She is an executive board member of AASSA-WISE committee since 2015. Attended various workshops in India, Turkey, Korea, Bangladesh, and. She was an executive member of Board of Studies, South Asian University from 2016-2018. She has presented her research work in 74 national and international workshops/conferences/symposiums.
Dr. Noshin Ilyas is an Associate Professor in the Department of Botany, PMAS Arid Agriculture University Rawalpindi, Pakistan. She has been always distinct in the academic carrier with a first-class first position in Masters and did Ph.D. under a fellowship from Higher Education Commission, Pakistan. She has supervised dissertational research work of 7 Ph.Ds and 31 M.Phil students. She has a good publication record in prestigious journals with an impact factor of above 173 and 1500 citations. She is an Academic Editor of PLoS One and guest editor of sustainability. She has earned several research grants from Higher Education Commission, Pakistan, and Pakistan Science Foundation. She is an active member of the scientific community and has presented her research work in various conferences in the country and abroad. She is president of Pakistan Asian PGPR society and a member of various professional societies. She has received Research Award in the female category of Assistant Professor from PMAS-Arid University, and 1st Prof. Dr. Abdul Hameed Gold Medal in Applied and Environmental Microbiology from Applied Zoological Society of Pakistan.
Chapter. 1. Potential of Streptomyces and its Secondary Metabolites for Biocontrol of Fungal Plant Pathogens.- Chapter. 2. Antifungal Secondary Metabolites against Blast Fungus - Magnaporthe oryzae.- Chapter. 3. Utilization of Plant Growth Promoting Bacteria (PGPB) Against Phytopathogens.- Chapter. 4. PGPR in Biofilm Formation and Antibiotic Production.- Chapter. 5. Plant Growth Promoting Rhizobacteria As Antifungal Antibiotics Producers.- Chapter. 6. Biofungicidal Properties of Rhizobacteria for Plant Growth Promotion and Plant Disease Resistance.- Chapter. 7. Antifungal Compounds of Plant Growth Promoting Bacillus species.- Chapter. 8. Bioactive Biomolecules from Plant Growth-Promoting Rhizobacteria (PGPR).- Chapter. 9. Metabolomic Profiling of Plant Growth Promoting Rhizobacteria for Biological Control of Phytopathogens.- Chapter. 10. Hydrolytic enzymes from PGPR against Plant Fungal Pathogens.- Chapter. 11. Induction of Hydrolytic Enzymes: A Criterion for Biological Control Candidates Against Fungal Pathogen.- Chapter. 12. Pseudomonas as Biocontrol Agent for Fungal Disease Management in Rice Crop.- Chapter. 13. Interaction of Mycorrhizal Fungi with Rhizospheric Microbes and their Mode of Action.- Chapter. 14. The Potential of Plant Growth Promoting Rhizobacteria (PGPR) as Biological Tools in Enhancing Agricultural Sustainability.- Chapter. 15. Role of Plant Growth Promoting Rhizobacteria (PGPR) in Food Security.- Chapter. 16. Plant-Microbe-Insect Interactions: Concepts and Applications for Agricultural Sustainability.- Chapter. 17. Exploring the Crucial Role of Plant Growth Promoting Rhizobacteria (PGPR) in Plant Secondary Metabolite Production and Diabetes management.
| Erscheinungsdatum | 30.08.2023 |
|---|---|
| Reihe/Serie | Fungal Biology |
| Zusatzinfo | XVIII, 380 p. 63 illus., 42 illus. in color. |
| Verlagsort | Cham |
| Sprache | englisch |
| Maße | 155 x 235 mm |
| Gewicht | 611 g |
| Themenwelt | Naturwissenschaften ► Biologie ► Genetik / Molekularbiologie |
| Naturwissenschaften ► Biologie ► Mikrobiologie / Immunologie | |
| Schlagworte | biomedicine • Biotechnology • Diagnostics • Fungal Infections • Markers • therapy |
| ISBN-10 | 3-031-04807-5 / 3031048075 |
| ISBN-13 | 978-3-031-04807-4 / 9783031048074 |
| Zustand | Neuware |
| Informationen gemäß Produktsicherheitsverordnung (GPSR) | |
| Haben Sie eine Frage zum Produkt? |
aus dem Bereich


